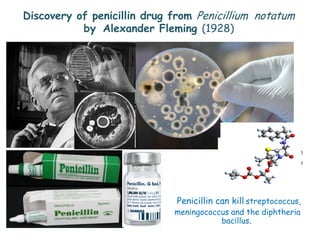
Penicillin can kill streptococcus,
meningococcus and the diphtheria
bacillus.
Discovery of penicillin drug from Penicillium notatum
by Alexander Fleming (1928)

This document discusses current trends in natural health products and research on natural products from garlic and perilla. It provides background on the history of using natural products for medicine beginning with Hippocrates prescribing garlic. Developments are discussed such as the discovery of antibiotics from microorganisms in the 1970s and shift to laboratory drug discovery in the 1980s. The presentation will cover organic chemistry, biochemistry, pharmacology and synthetic analogs related to natural product research and development. Studies on garlic are summarized showing that consuming garlic may help lower blood glucose, cholesterol, and triglycerides.

![ALA, EPA and DHA and Their Health Benefits
• The three types of omega-3 fatty acids involved in
human physiology are ALA (found in plant oils), EPA,
and DHA (both commonly found in marine oils).
• Marine algae and phytoplankton are primary sources of
omega-3 fatty acids. Common sources of plant oils
containing the omega 3 ALA fatty acid include walnut,
edible seeds, clary sage seed oil, algal oil, flaxseed oil,
Sacha Inchi oil, Echium oil, and hemp oil, while sources
of animal omega-3 EPA and DHA fatty acids include fish
oils, egg oil, squid oils, and krill oil.
• Supplementation with omega-3 fatty acids does not
appear to affect the risk of death, cancer or heart
disease.[3][4]
55
Ref: Omega-3 fatty acid - Wikipedia, the free encyclopedia.html#cite_note-
CL2005-80](https://image.slidesharecdn.com/27b4fb29-9de8-4f40-ac24-bb83b4ed11bf-160704020540/85/Maitree-slides-for-WCCN2014-55-320.jpg)







